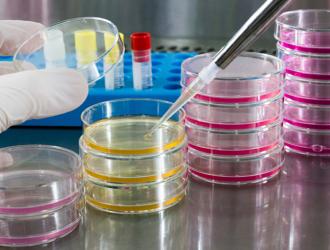

Mentre la Sicilia è l’unica regione rossa in Italia e i Siciliani, almeno quelli di buona volontà, sono fortemente condizionati dalle limitazioni imposte per contenere i contagi e l’economia langue, abbiamo deciso di rivolgerci ad una fonte autorevole del mondo della infettivologia siciliana per...
servizio sanitario
Il prestigioso British Medical Journal ha pubblicato i risultati della ricerca realizzata da CIPOMO (Collegio Italiano dei Primari Oncologi Medici Ospedalieri) nei confronti dei propri associati sul delicato tema del conflitto d'interessi.
Obiettivo della survey, dal...
Comunicato stampa
Roma, 16 giugno 2017
Tribunale per i diritti del malato-Cittadinanzattiva su medicina convenzionata: rivedere l’atto di indirizzo per sbloccare lo stallo del rinnovo delle convenzioni e rispondere meglio alle esigenze dei cittadini
«Sono anni che...
Comunicato stampa
Roma, 15 maggio 2017
Cittadinanzattiva-Tribunale per i diritti del malato: raccolte oltre 35mila firme di cittadini per l'abolizione del superticket. Si abolisca subito e non si faccia cassa col ticket sui codici verdi in pronto soccorso
...Sono sempre di più i casi di malasanità in Italia e purtroppo il Bel Paese registra un pessimo primato a riguardo. Vediamo nel dettaglio qual è il quadro generale della situazione italiana. Partendo dal presupposto che con malasanità si intendono tutti quei casi il cui epilogo è spesso il decesso a causa di errori,...